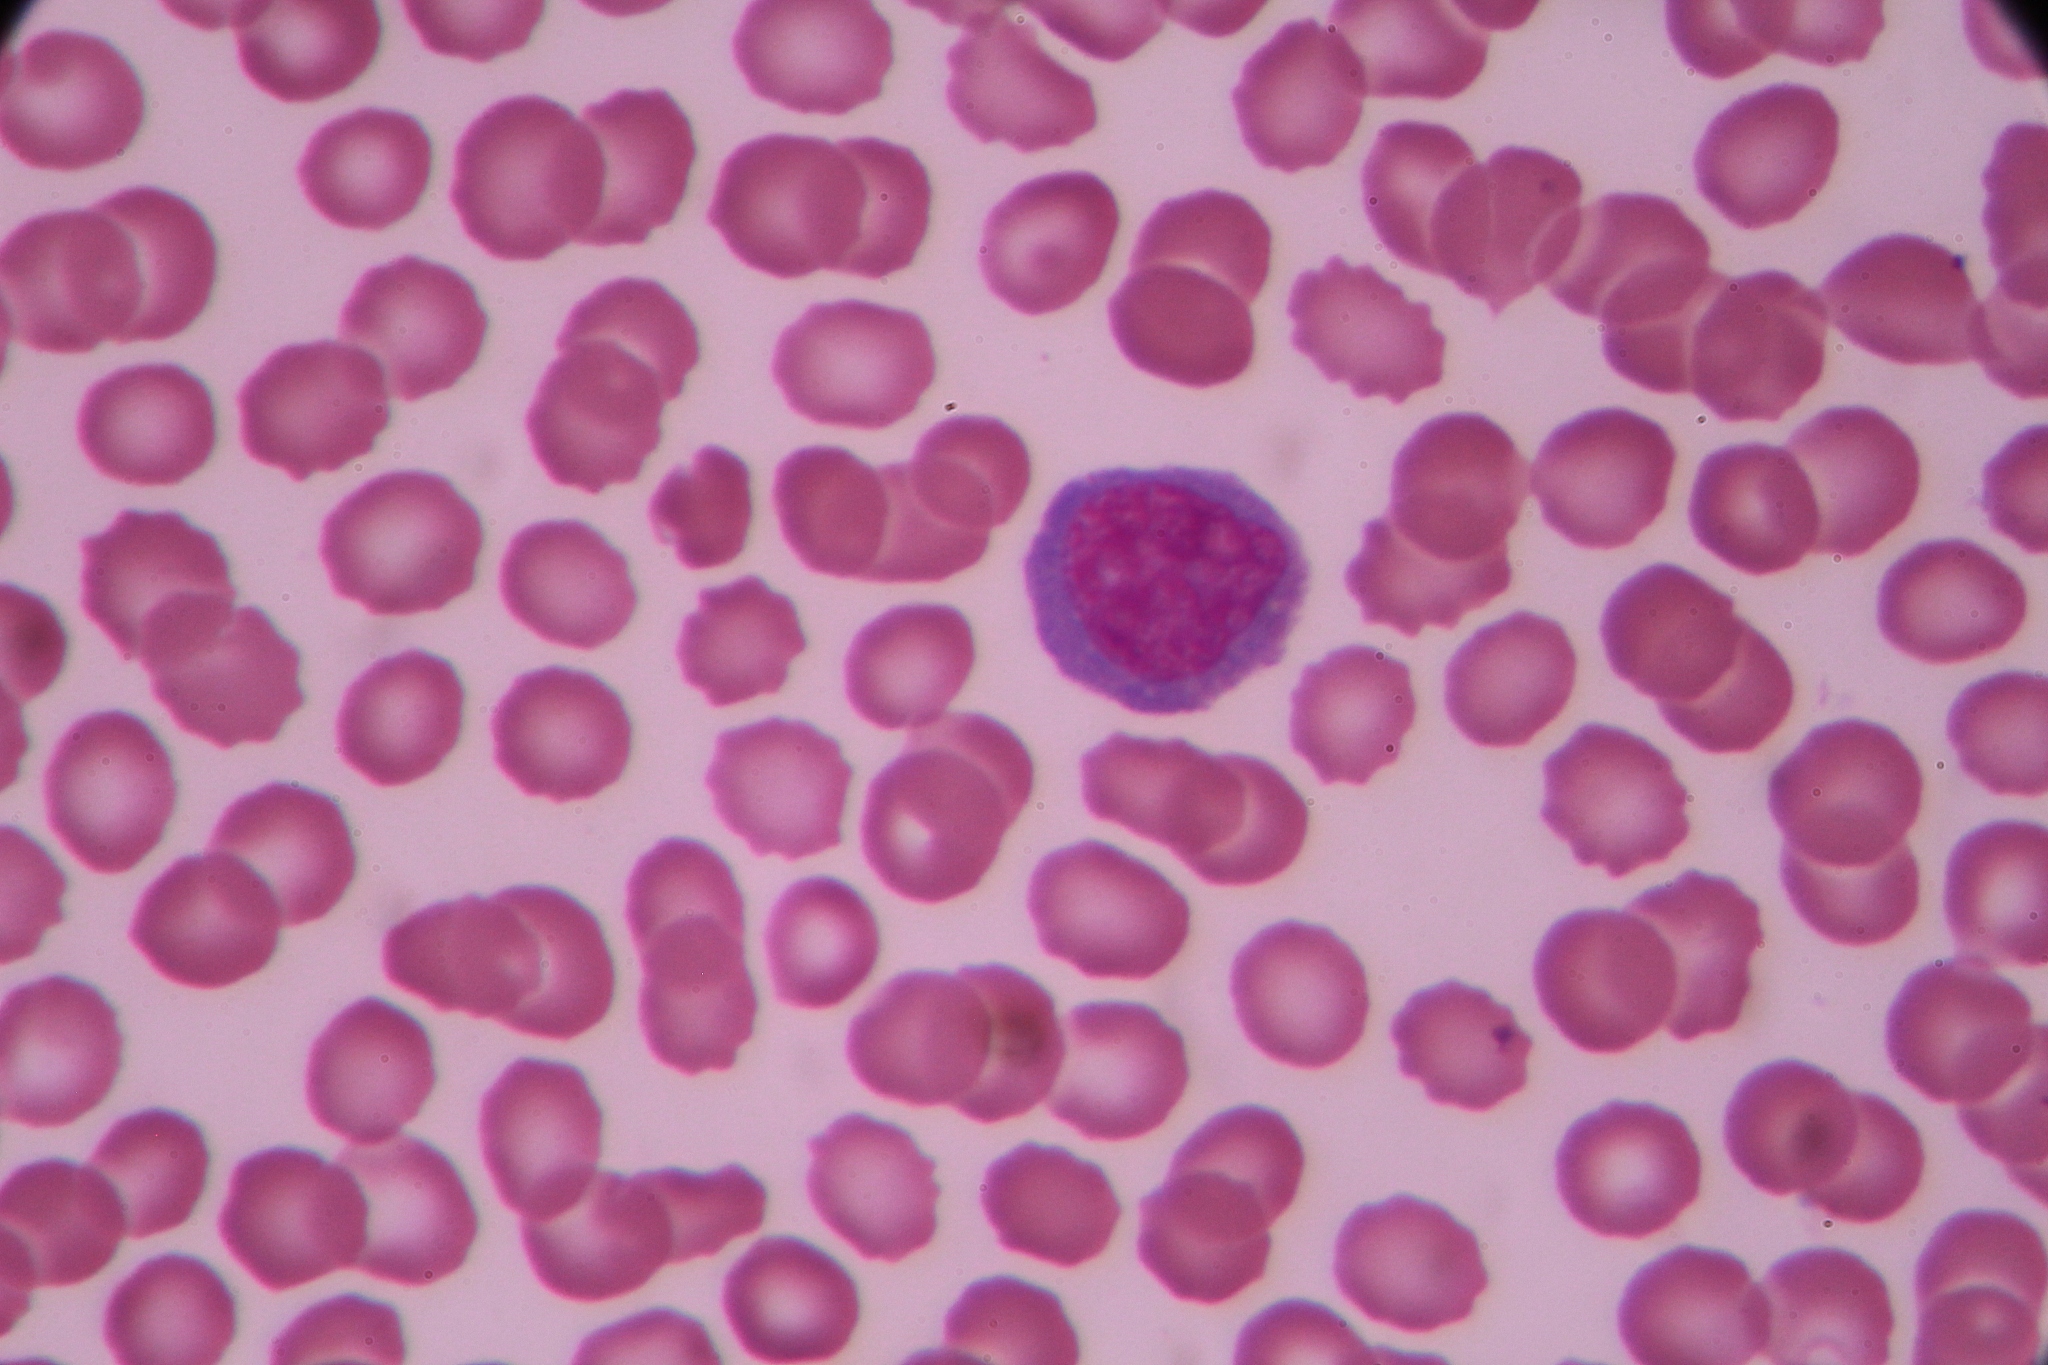

白细胞三分类是根据细胞的实际大小进行分类。正确么
错误。白细胞的三分类是根据细胞核的形态和染色性质进行分类,包括粒细胞、淋巴细胞和单核细胞。细胞的大小并不是分类的依据。

原文地址: http://www.cveoy.top/t/topic/J2e 著作权归作者所有。请勿转载和采集!
安全问答是一个知识全球问答,包含丰富的问答知识
错误。白细胞的三分类是根据细胞核的形态和染色性质进行分类,包括粒细胞、淋巴细胞和单核细胞。细胞的大小并不是分类的依据。
原文地址: http://www.cveoy.top/t/topic/J2e 著作权归作者所有。请勿转载和采集!